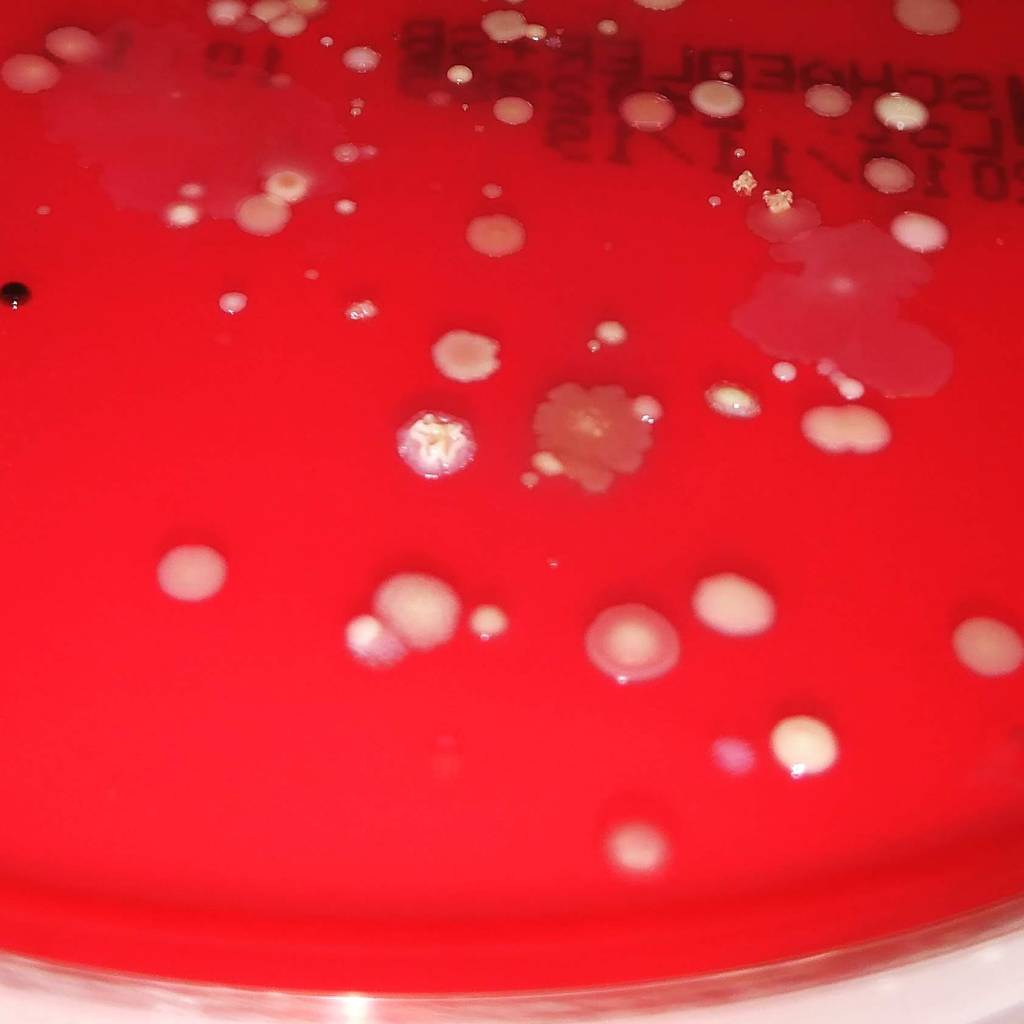

Ya hace 10 años que ando cacharreando en uno de los laboratorios de la Universidad de Santiago de Compostela. Empecé porque había flipado con las bacterias y me apasionaba la idea de poder no solo conocer las cosas increíbles de las que son capaces sino también comprender cómo lo hacen y por qué. El hecho de saber que mis pequeños y humildes experimentos serán útiles en algún momento para la sociedad no hace sino contribuir al hecho de que me encante mi trabajo.
Al contrario de lo que se pueda creer no existe una única forma de hacer ciencia. Ya que la ciencia es una forma de pensar, es una forma de entender este mundo tan raro en el que vivimos desde un punto de vista lógico y racional. Y esto se puede hacer de varias formas: ciencia inductiva o empirismo (a partir de observaciones particulares se llegan a conclusiones generales) y ciencia deductiva o racionalismo (una conclusión general se aplica a un fenómeno particular). Ambos métodos son totalmente válidos y es que algunas disciplinas requieren usar una forma de hacer la ciencia u otra.
En las noticias científicas no se suele poner de forma explícita que tipo de ciencia es la que se lleva a cabo. Sin embargo, podemos darle un poco al «coco» e intentar pensarlo por nosotros mismos. Por ejemplo:

En la Universidad de Granada han visto que la actividad física en niños con sobrepeso y obesidad aumenta la cantidad de materias gris en el cerebro, en concreto en regiones esenciales para la memoria de trabajo y el aprendizaje. Aunque en el texto no se diga específicamente entiendo que este es un trabajo de ciencia inductiva ya que a partir de las observaciones de estos niños se puede especular que el cerebro funcione mejor al realizar deporte.
Unos investigadores daneses encontraron un chicle (en realidad es una resina de abedul) de hace 6.000 años que les permitió no solo conocer las características físicas de la chica que se lo tomó sino también que tipo de alimentación tenía y algunas enfermedades que padecía. Esto fue posible porque encontraron restos de su ADN pero también ADN de bacterias de su boca en el chicle. En mi opinión es un caso de ciencia deductiva, ya que a partir del análisis de las secuencias de ADN encontradas en restos fósiles los investigadores determinaron cómo era la chica y algunas de las circunstancias en las que vivía viendo si encajaba en el modelo previsto.

Nuevos estudios parecen indicar que el estallido del volcán Toba no tuvo esa importancia que se pensaba en el gran descenso de la población humana (quedando solamente en unos miles de individuos). La aparición de nuevos restos fósiles durante los últimos años está ayudado a reconstruir poco a poco que le sucedió a las poblaciones cazadoras-recolectoras que aunque sobrevivieron al estallido del volcán Toba acabaron despareciendo. En este caso, estaríamos hablando de ciencia deductiva ya que no es posible realizar experimentos con especies extintas.
Un proyecto liderado por un científico español y llevado a cabo por un equipo de la NASA pretende que sea posible cultivar las primeras plantas comestibles en la Luna en el año 2024. Para ello realizaron sus experimentos en el módulo europeo de la Estación Espacial Internacional con los que pretendían entender qué les pasa a las células y a los genes de las plantas en el espacio para así poder establecer la mejor estrategia de cultivo. Este es un ejemplo de ciencia inductiva ya que a partir de las observaciones obtenidas con los experimentos realizados se puede llegar a una conclusión.

